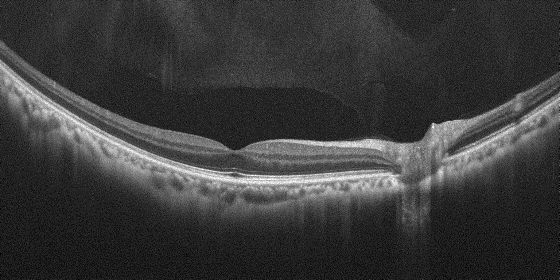

キヤノンは、眼科機器の新製品として、OCT※1と眼底カメラの機能を有する光干渉断層計“OCT-R1”およびデジタル眼底カメラ“CR-10”を2023年10月下旬に発売する。



OCTは、近赤外光を利用して網膜の断層像を撮影する眼科機器で、眼科や健診などで、近年増加している緑内障や加齢黄斑変性など眼の疾患の診断や経過観察に用いられている。眼底カメラは、目の奥の網膜や血管を撮影し、さまざまな眼の疾患の観察に用いられ、さらに、生活習慣病などの健診では、高血圧性変化による動脈硬化の検査などにも広く活用されている。新製品はいずれも、タッチパネルを用いて、左右の眼の撮影から表示までを自動で行うことが可能だ※2。これにより、撮影者のスキルに頼らない効率的な検査の実現に貢献する。
タッチ操作で左右眼の画像撮影を自動で行い効率的な検査を実現
“OCT-R1”と“CR-10”はいずれも、タッチパネルを用いた簡単な操作で、左右の眼の撮影から検査結果の表示までを自動で行うことができるオート撮影機能を搭載している。また、撮影時に被検者を音声で誘導する音声ガイダンス機能を搭載し、撮影者のスキルに頼らず正しく簡単に撮影ができるようサポートする。
高画質で広画角のOCT/OCTA※3撮影を実現
“OCT-R1”は、OCTにおいて従来機種※4を上回るスキャン幅約14.7mm、深さ約13.4mmの広画角撮影を実現している。広範囲を一度の撮影で高精細に画像化できるため、眼底の周辺における病変の発見などに貢献する。さらに、眼底の三次元画像から画像処理技術を用いて血管形態を抽出するOCTAの撮影も可能だ。
省スペースでフレキシブルなレイアウト配置が可能
“OCT-R1”と“CR-10”はいずれも本体を小型化し、PCなどの必要な付属品を光学台※5にコンパクトにまとめたことにより、省スペースでフレキシブルなレイアウトが可能だ。
※1. Optical Coherence Tomography(光干渉断層計)の略。
※2. “OCT-R1”はOCT/OCTA と眼底カメラ、“CR-10”は眼底カメラのオート撮影が可能。OCTA(Optical Coherence Tomography Angiography)は、眼底三次元画像から血管形態を抽出する画像処理技術。
※3. 最大約13.4×約13.4mm の広画角撮影をOCTAで行うためには有償ライセンスが必要。
※4. 「OCT-A1」(2019年4月発売)
※5. 眼科機器を搭載するための電動昇降テーブル。
| 製品名 | 希望小売価格(税別) | 発売日 |
| 光干渉断層計 OCT-R1 | 1,080万円 | 2023年10月下旬 |
| デジタル眼底カメラ CR-10 | 430万円 | 2023年10月下旬 |
主な特長
1)タッチ操作で左右眼の画像撮影を自動で行い効率的な検査を実現
⚫“OCT-R1”と“CR-10”はいずれも、新たに開発したタッチパネル式のユーザーインターフェースを搭載。眼が写った画面をタッチするだけで、装置が撮影位置の調整を自動で行い、撮影中の眼の動きを自動で追尾し、撮影するオート撮影※が可能。
⚫タッチパネルを用いた簡単な操作で、左右の眼の撮影から検査結果の一覧表示までを自動で行うことができるため、撮影者のスキルに頼らず撮影が可能。さらに、撮影に失敗した画像を自動判定し、確認画面に表示。再撮影をワンタッチで簡単に行うことも可能。
⚫撮影時に被検者を音声で誘導する音声ガイダンス機能を搭載。日本語のほか、英語など計7言語に対応。日本語以外でのガイダンスが可能なため、さまざまな被検者の方の撮影をサポートすることが可能。
※“OCT-R1”はOCT/OCTA と眼底カメラ、“CR-10”は眼底カメラのオート撮影が可能。OCTA(Optical Coherence Tomography Angiography)は、眼底三次元画像から血管形態を抽出する画像処理技術。

2)高画質で広画角のOCT/OCTA撮影を実現
⚫“OCT-R1”は、OCT断層像とカラー眼底写真を一度のワンタッチ操作で撮影が可能。OCTにおいては従来機種上回るスキャン幅約14.7mm、深さ約13.4mm の広画角撮影を実現。広範囲を一度の撮影で高精細に画像化できるため、病変の早期発見などに貢献。
⚫高画質なOCT の断層像により、脈絡膜から網膜、硝子体の状態を観察することが可能。眼科系疾患の診断・治療方針の決定などに貢献。
⚫眼底の三次元画像から画像処理技術を用いて血管形態を抽出するOCTAの撮影が可能。AIによるノイズ低減処理機能「Intelligent denoise※」を搭載し、ノイズの少ない高画質なOCTA画像を簡単に取得することが可能。
※本システムは設計段階でディープラーニング技術を用いており、本システム自体に自己学習機能は有していない。
3)省スペースでフレキシブルなレイアウト配置が可能
⚫“OCT-R1”と“CR-10”はいずれも本体を小型化し、PCなどの必要な付属品を光学台にコンパクトにまとめたことにより、省スペースでフレキシブルなレイアウトが可能。
⚫ディスプレイの位置を使用環境によって変更できるため、撮影者と被検者がL字型もしくは横並びでの配置も可能。


ご参考
2023年10月6日(金)から9日(月・祝)まで東京国際フォーラムで開催される「第77回日本臨床眼科学会」において、“OCT-R1”および“CR-10”を展示予定だ。
製品仕様について
製品仕様の詳細はキヤノンホームページを参照。https://mts.medical.canon/
| 一般的名称 | 眼撮影装置、眼底カメラ |
| 販売名 | 光干渉断層計 OCT-R1 |
| 認証番号 | 305ABBZX00029000 |
| 一般的名称 | 眼底カメラ |
| 販売名 | デジタル眼底カメラ CR-10 |
| 認証番号 | 305ABBZX00025000 |
お問い合わせ
キヤノンメドテックサプライ株式会社
⚫ 一般の方のお問合せ先
https://mts.medical.canon/_inquiry/
⚫ 眼科機器ホームページ
https://mts.medical.canon/ophthalmic/lineup/

